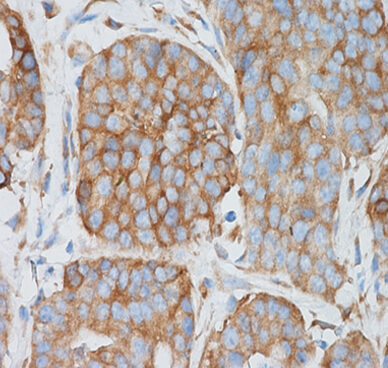

- La concientización del cáncer de mama es importante porque permite detectar la enfermedad en etapas tempranas, cuando el tratamiento es más efectivo y con menor impacto en el bienestar general de la paciente.
- Estudiar esta patología permite comprender sus mecanismos moleculares, mejorar terapias, identificar factores de riesgo y desarrollar estrategias de prevención. Es clave para reducir la mortalidad y avanzar hacia tratamientos personalizados y más eficaces.
- En nuestro laboratorio investigamos cómo el cáncer de mama progresa y se vuelve resistente a los tratamientos hormonales. Nos enfocamos en una hormona llamada progesterona y en sus receptores, que pueden activar genes relacionados con el crecimiento del tumor. Hemos visto que, según el tipo y proporción de estos receptores, la progesterona puede estimular o frenar el cáncer. Por eso, buscamos identificar qué pacientes podrían beneficiarse de terapias específicas. También estudiamos cómo se genera la resistencia a los tratamientos, para encontrar nuevas formas de combatirla.
- Buscamos generar conocimiento que contribuya a mejorar el diagnóstico y tratamiento del cáncer de mama, especialmente en casos resistentes a la terapia hormonal. Nuestro objetivo es avanzar hacia terapias más efectivas y personalizadas, que beneficien directamente a pacientes.